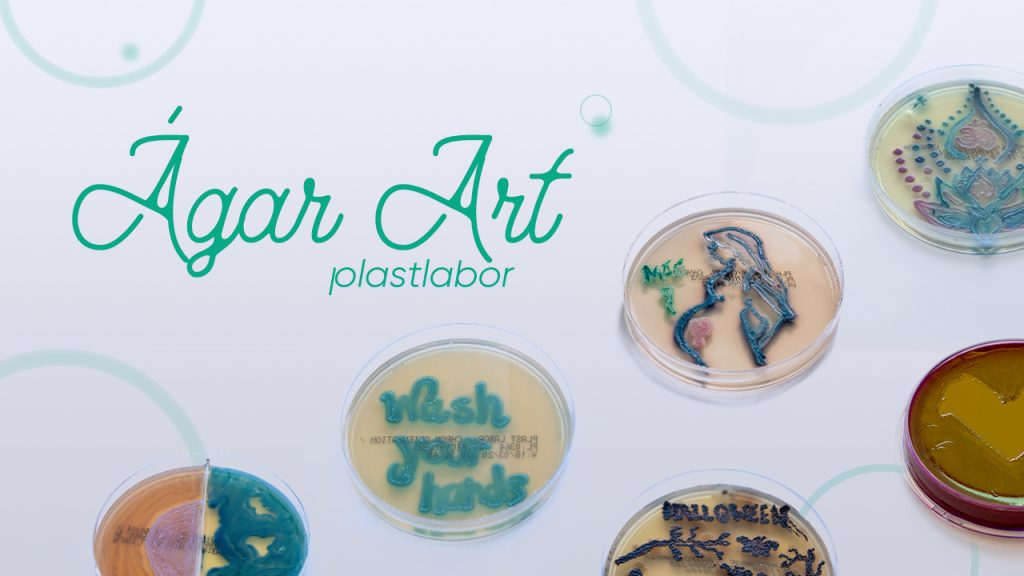

Análise de Legionella em sistemas de água

O surto de Legionella na Argentina, reacendeu o alerta para a importância da análise periódica da água e da necessidade de seguir as orientações descritas na NBR 16824:2020.
Aleitamento materno e padrões microbiológicos

O leite materno é o melhor e principal alimento nos primeiros seis meses de vida, pois ele concentra todos os nutrientes que o bebê precisa. Além de alimentar, o leite materno também protege contra doenças.
Nota Técnica alerta para aumento de bactérias multirresistentes

Nota Técnica assinada pela pela CGLAB, pelo BrCAST e pela Anvisa, alerta para o aumento na frequência de isolamento de bactérias multirresistentes
Sepse uma doença silenciosa que precisa de atenção

No Brasil, estima-se que anualmente 240 mil pessoas cheguem a óbito devido a complicações causadas pela sepse. Esse número afeta principalmente recém-nascidos, crianças e idosos. Entretanto, a sepse afeta também pessoas com algum grau de deficiência no sistema imune. Um dos fatores para esse número elevado é a falta de tratamento antibacteriano e ferramentas para […]
Controle Microbiológico de Comésticos

Segundo a RDC 48/2013 “os produtos de higiene pessoal, cosméticos e perfumes devem ser seguros nas condições normais ou previsíveis de uso”.
Controle de qualidade na Indústria de Alimentos

A Indústria de Alimentos, uma das cadeias produtivas mais sensíveis, ganhou destaque na mídia nos últimos dias devido ao fechamento temporário da fábrica Ferrero, na Bélgica, após denúncias de possíveis surtos de contaminação do produto Kinder Ovo, pela Salmonella Typhimurium. Segundo o jornal britânico Daily Mail, o ponto de origem da bactéria foi identificado como […]
Dia Mundial de Combate à Tuberculose

O último relatório da OMS registrou que mais de quatro mil pessoas morreram e quase 30 mil pessoas foram diagnosticadas…
A importância da análise microbiológica na indústria da água

No Dia Mundial da Água, a ONU alerta para a necessidade de proteger as águas subterrâneas, devido ao crescimento populacional, às crescentes demandas da agricultura e indústria, e principalmente, com o agravamento das mudanças climáticas.
Desafios atuais e futuros no mercado diagnóstico e industrial

O CEO da Plastlabor, Wagner Garcia, na edição nº 254, da revista Laes & Haes, traçou um panorama de como enfrentar os desafios atuais e futuros no mercado de diagnóstico e industrial
Concurso Ágar Art Plastabor
Em novembro, a Plastlabor completa 34 anos de atuação no segmento de Meios de Cultura prontos para uso. Para comemorar esse período de muito trabalho e inovações, a empresa lançou o concurso Ágar Art.
Semana Mundial de Conscientização Antimicrobiana

A resistência antimicrobiana (RAM) põe em risco a eficácia da prevenção e do tratamento de um número cada vez maior de infecções por vírus, bactérias, fungos e parasitas.
Webinar: Controle de Qualidade no Laboratório Clínico e Molecular

Confira os conteúdos do webinar: Controle de Qualidade no Laboratório Clínico e Molecular